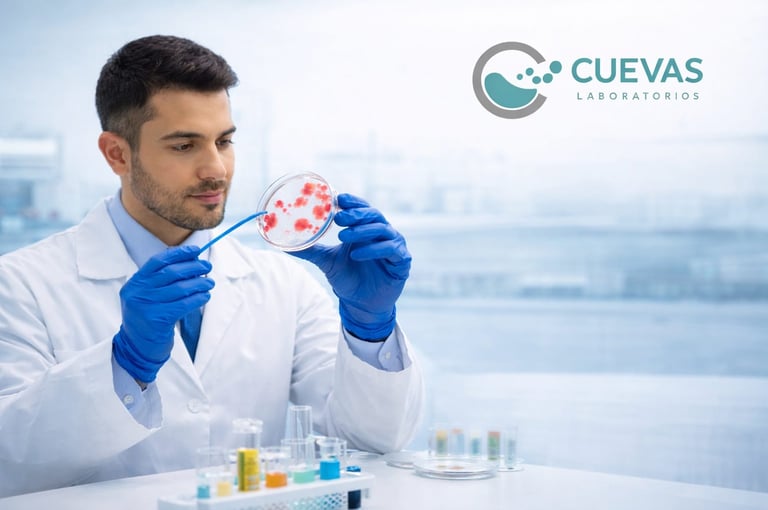

Servicio de Microbiología
En Cuevas Laboratorios ofrecemos el servicio de microbiología, un área del análisis clínico enfocada en la detección e identificación de microorganismos que pueden causar diversas infecciones en el organismo. A través de estudios microbiológicos es posible analizar la presencia de bacterias, hongos y otros agentes infecciosos en diferentes muestras biológicas como sangre, orina, heces, secreciones o tejidos.